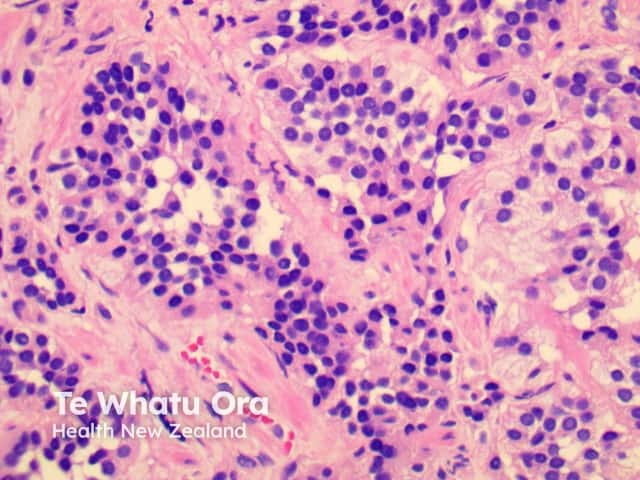
Figure 5

Main menu
Common skin conditions
NEWS
Join DermNet PRO
Read more
Quick links
Lesions (cancerous) Diagnosis and testing
Authors: Dr Achala Liyanage, Dermatology Fellow, Waikato Hospital, Hamilton, New Zealand; Assoc Prof Patrick Emanuel, Dermatopathologist, Auckland, New Zealand. January 2015.
Cutaneous carcinoid tumours represent metastases from primaries in the lung or gastrointestinal system.
Cutaneous features of carcinoid syndrome including flushing, rosacea, scleroderma and pellagra.
Microscopically tumours are composed of solid islands and nests of uniform cells. Thin collagenous septa extend between the tumour nests.

Figure 1

Figure 2

Figure 3

Figure 4
Figure 5

Figure 6

Figure 7

Figure 8
Images provided by Dr Duncan Lamont, Waikato Hospital
Tumour cells are positive for neuron-specific enolase, chromogranin and synaptophysin.
On electron microscopy dense-core granules can be seen in the cytoplasm.
Primary adnexal poroid neoplasm
Hailey-Hailey disease